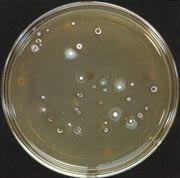
�����з��߾���ƽ�����

|
放线菌与人类的关系极为密切。人们到医院去看病,医生根据病人的病因,往往开些链霉素、土霉素、四环素、氯霉素、红霉素、庆大霉素等抗生素药物,这些抗生素药物都是放线菌为我们制造的。至今从微生物中发现了几千种抗生素,其中2/3是由放线菌产生的。有些放线菌还用于生产维生素和酶制剂、处理污水等。所以,虽然有几种放线菌引起人、动物、植物的疾病,如引起人的皮肤和肺部得病,但大多数放线菌却对防治人、畜和植物的病害立下了丰功伟绩。 放线菌与人类的关系极为密切。人们到医院去看病,医生根据病人的病因,往往开些链霉素、土霉素、四环素、氯霉素、红霉素、庆大霉素等抗生素药物,这些抗生素药物都是放线菌为我们制造的。至今从微生物中发现了几千种抗生素,其中2/3是由放线菌产生的。有些放线菌还用于生产维生素和酶制剂、处理污水等。所以,虽然有几种放线菌引起人、动物、植物的疾病,如引起人的皮肤和肺部得病,但大多数放线菌却对防治人、畜和植物的病害立下了丰功伟绩。
放线菌实际上是细菌家族中的一员,是一类具有丝状分枝细胞的革兰氏阳性细菌,因菌落呈放射状而得名。放线菌最喜欢生活在有机质丰富的微碱性土壤中,泥土所特有的"泥腥味"就是由放线菌产生的。
用干燥、加热和药剂处理等选择性分离方法,可以从土壤中挑选出我们所需要的有益放线菌菌种。

|